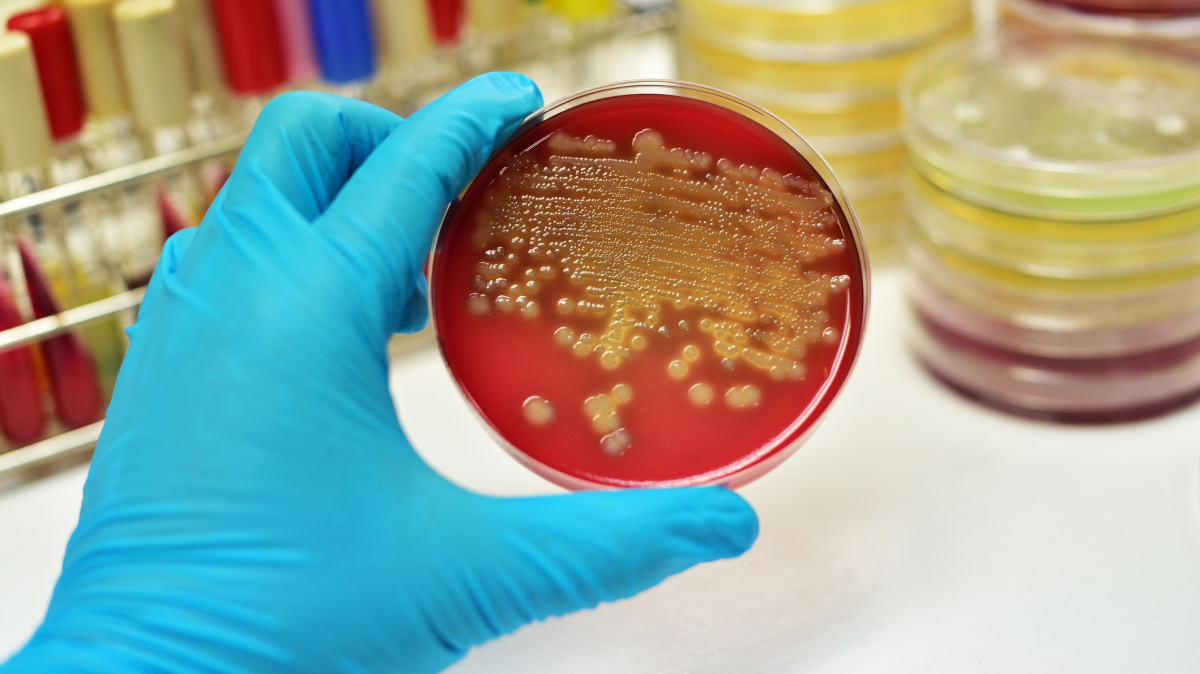

Články autora: Ladislav Loukota
Technologie
Vědci vytvořili rotační nanomotor z kroužků DNA. Jde o zcela novou formu pohybu
14. 4. 2018
|
Ladislav Loukota
I když pojem "nanotechnogie" létá éterem již zhruba po dvě desetiletí, stále je toho mnoho, co molekulární stroje uspokojivě nezvládnou. Částečně neprobádaným teritoriem je například mechanický pohyb. Během novému výzkumu německo-amerického týmu Michiganské univerzity a Bonnské univerzity se však nově podařilo vyvinout zcela novou formu pohybu nanostrojů. Vědci totiž vytvořili primitivní rotační motor, který dovede molekulární jednokolku rozpohybovat specifickým směrem.
Technologie
Implantáty vylepšující paměť úspěšně prošly prvními testy na lidech
10. 4. 2018
|
Ladislav Loukota
Snad jenom málokdo se může pochlubit bezproblémovou pamětí. Nejde pouze o přirozené zhoršování naší schopnosti vybavit si znovu vzpomínky – paměť je likvidována i celou řadou neurologických chorob. Právě těmto pacientům nyní dává naději první úspěšná demonstrace paměťového implantátu zlepšujícího "externě" schopnost znovuvyvolání vzpomínek, který předvedli vědci na americkém Wake Forest Baptist Medical Center.
Technologie
NASA vyvíjí štít, který by chránil kosmické lodě před radiací
8. 4. 2018
|
Ladislav Loukota
Před cestováním do hlubokého kosmu nám stojí ještě řada překážek. Dost možná tou nejvýznamnější je však radiace - významnou hrozbu představují jak kosmické záření bičující vesmír konstantně, tak i extrémní vlny radiace přicházející čas od času. Zatímco na Zemi nás před zářením (povětšinou) chrání magnetosféra, ochrana v kosmu by vyžadovala nezměrné tuny nákladu v podobě tlustších plášťů lodí. Možná však existuje ještě jeden způsob – magnetosféra umělá. Na cestě k ní nyní NASA udělala krok kupředu.
Technologie
Vědci se trochu 'sekli': Genový editor CRISPR nechtěné mutace nakonec nezpůsobuje
3. 4. 2018
|
Ladislav Loukota
Loni v květnu zatajil svět genetiky dech - objevila se totiž studie, podle níž vykazuje genový editor CRISPR daleko vyšší míru vedlejších účinků, než se do té doby myslelo. CRISPR je přitom opěvován jako potenciální "zázračný" nástroj medicín budoucnosti, který při editaci DNA oplývá doslova chirurgickou přesností. Za deset měsíců je vše jinak. Nikdo nebyl totiž s to replikací někdejší studie prokázat, že by CRISPR skutečně byl podobně chybový, a to včetně jejích původních autorů.
Vesmír
Nebeský palác 1 shořel. Je to velké vítězství čínského kosmického programu
2. 4. 2018
|
Ladislav Loukota
V pondělí nad ránem našeho času do atmosféry konečně vstoupila čínská kosmická stanice Nebeský palác 1. Stalo se tak po týdnech sledování jejích posledních oběhů Země, a po víc než roce a půl od (údajné) ztráty kontroly nad stanicí. Ačkoliv i ze samotné Číny přicházely rozporuplné zprávy nad tím, nakolik je Nebeský palác 1 stále v moci řídícího střediska, stanice nakonec dle plánů sestoupila nad Tichomořím. Je to velké technické i propagandistické vítězství čínského kosmického programu.
Člověk
'Prázdný' sarkofág po 150 letech odhalil egyptskou mumii
1. 4. 2018
|
Ladislav Loukota
I když archeologové jistý dřevěný sarkofág nalezli již v průběhu zlatého věku egyptologie v 19. století, po víc než 150 let ho měli za prakticky bezcenný. Když jej totiž po jeho (znovu)odhalení otevřeli, byl prázdný. A tak na artefakt sedal prach ve skladištích univerzity v Sydney. Moderní technologie však ukázaly, že uvnitř třímal vědecký poklad - doposud neobjevená starověká mumie.
Technologie
Nový lék z Harvardu 'omladil' cévy pokusných zvířat
31. 3. 2018
|
Ladislav Loukota
Různé zaručené elixíry nesmrtelnosti jsou tak staré, jako strach ze smrti sám. Čím dál častěji však také moderní věda tvrdí, že je na stopě když ne věčnému životu, tak alespoň dílčímu omlazení organismu. Testování přípravků z dílny vědců Harvardovy univerzity na zvířatech nyní prokázalo, že specificky vytvořené léky mohou umazat vnější znaky cévního stárnutí. V unikátním pokusu se podařilo obnovit růst cév, posílit svalovou vitalitu a efektivitu organismu během fyzické námahy.
Příroda
LUCA opět ožívá. Vědci znovuvytvořili nejstarší známý život na Zemi
25. 3. 2018
|
Ladislav Loukota
Naše planeta byla mladá a ještě doutnala po posledním impaktu pozdního velkého bombardování, když kdesi v oceánech vznikl z anorganických chemických reakcí náš nejstarší společný předek - skutečně živá bytost. Tento hypotetický jednobuněčný organismus dnešní evoluční teorie nazývají Poslední univerzální společný předek alias LUCA (Last Universal CommonAncestor). Vědcům z univerzity v Groningenu se jej však nyní podařilo znovu přivést k životu.